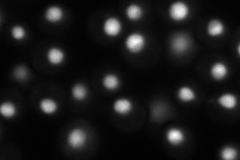
YMR043W
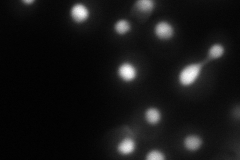
YMR043W

View description
Transcription factor involved in cell-type-specific transcription and pheromone response; plays a central role in the formation of both repressor and activator complexes
Localization:
Intensity:
Fold change:
Significance:
-
C’ GFP library in SD

nucleus58.88 -
N' NOP1pr-GFP in SD
nucleus87.9866 -
N' TEF2pr-mCherry in SD
nucleus101.571 -
N' NATIVEpr-GFP in SD

nucleus62.0554 -
N' TEF2pr-VC and Cyto-VN in SD

nucleus31.4263 -
C’ GFP library in SD+DTT

nucleus45.770.77No -
C’ GFP library in SD+H2O2

nucleus54.90.93No -
C’ GFP library in Starvation Media

nucleus46.30.78No -
C’ GFP library on the background of Pup2-DaMP

nucleus -
C’ GFP library on the background of CCT mutant

nucleus46.88330.796112No
